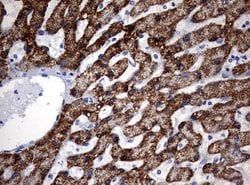
Img

50-166-6060
KRT20 Mouse anti-Human, Clone: OTI2A2, lyophilized, TrueMAB™
Manufacturer: OriGene
Select a Size
| Pack Size | SKU | Availability | Price |
|---|---|---|---|
| Each of 1 | 50-166-6060-Each-of-1 | In Stock | ₹ 60,342.00 |
50-166-6060 - Each of 1
In Stock
Quantity
1
Base Price: ₹ 60,342.00
GST (18%): ₹ 10,861.56
Total Price: ₹ 71,203.56
Antigen
KRT20
Classification
Monoclonal
Conjugate
Unconjugated
Gene
KRT20
Gene Alias
CD20, CK-20, CK20, K20, KRT21
Host Species
Mouse
Purification Method
Affinity Chromatography
Regulatory Status
RUO
Gene ID (Entrez)
54474
Content And Storage
-20° C, Avoid Freeze/Thaw Cycles
Form
Lyophilized
Applications
Immunohistochemistry (Paraffin), Western Blot
Clone
OTI2A2
Formulation
PBS with 8% trehalose and no preservative; pH 7.3
Gene Accession No.
P35900
Gene Symbols
KRT20
Immunogen
Full length human recombit protein of human KRT20 produced in E.coli.
Quantity
100 μg
Primary or Secondary
Primary
Target Species
Human
Product Type
Antibody
Isotype
IgG2a
Description
- Reconstitute with PBS (pH 7.3) and recommend to perform another round of desalting process using Product No
- 7KMWCO The protein encoded by this gene is a member of the keratin family
- The keratins are intermediate filament proteins responsible for the structural integrity of epithelial cells and are subdivided into cytokeratins and hair keratins
- The type I cytokeratins consist of acidic proteins which are arranged in pairs of heterotypic keratin chains
- This cytokeratin is a major cellular protein of mature enterocytes and goblet cells and is specifically expressed in the gastric and intestinal mucosa
- The type I cytokeratin genes are clustered in a region of chromosome 17q12-q21.
Compare Similar Items
Show Difference
Antigen: KRT20
Classification: Monoclonal
Conjugate: Unconjugated
Gene: KRT20
Gene Alias: CD20, CK-20, CK20, K20, KRT21
Host Species: Mouse
Purification Method: Affinity Chromatography
Regulatory Status: RUO
Gene ID (Entrez): 54474
Content And Storage: -20° C, Avoid Freeze/Thaw Cycles
Form: Lyophilized
Applications: Immunohistochemistry (Paraffin), Western Blot
Clone: OTI2A2
Formulation: PBS with 8% trehalose and no preservative; pH 7.3
Gene Accession No.: P35900
Gene Symbols: KRT20
Immunogen: Full length human recombit protein of human KRT20 produced in E.coli.
Quantity: 100 μg
Primary or Secondary: Primary
Target Species: Human
Product Type: Antibody
Isotype: IgG2a
Antigen:
KRT20
Classification:
Monoclonal
Conjugate:
Unconjugated
Gene:
KRT20
Gene Alias:
CD20, CK-20, CK20, K20, KRT21
Host Species:
Mouse
Purification Method:
Affinity Chromatography
Regulatory Status:
RUO
Gene ID (Entrez):
54474
Content And Storage:
-20° C, Avoid Freeze/Thaw Cycles
Form:
Lyophilized
Applications:
Immunohistochemistry (Paraffin), Western Blot
Clone:
OTI2A2
Formulation:
PBS with 8% trehalose and no preservative; pH 7.3
Gene Accession No.:
P35900
Gene Symbols:
KRT20
Immunogen:
Full length human recombit protein of human KRT20 produced in E.coli.
Quantity:
100 μg
Primary or Secondary:
Primary
Target Species:
Human
Product Type:
Antibody
Isotype:
IgG2a
Antigen: KRT20
Classification: Monoclonal
Conjugate: Unconjugated
Gene: KRT20
Gene Alias: CD20, CK-20, CK20, K20, KRT21
Host Species: Mouse
Purification Method: Affinity Chromatography
Regulatory Status: RUO
Gene ID (Entrez): 54474
Content And Storage: -20° C, Avoid Freeze/Thaw Cycles
Form: Lyophilized
Applications: Immunohistochemistry (Paraffin), Western Blot
Clone: OTI4B4
Formulation: PBS with 8% trehalose and no preservative; pH 7.3
Gene Accession No.: P35900
Gene Symbols: KRT20
Immunogen: Full length human recombit protein of human KRT20 produced in E.coli.
Quantity: 100 μg
Primary or Secondary: Primary
Target Species: Human
Product Type: Antibody
Isotype: IgG1
Antigen:
KRT20
Classification:
Monoclonal
Conjugate:
Unconjugated
Gene:
KRT20
Gene Alias:
CD20, CK-20, CK20, K20, KRT21
Host Species:
Mouse
Purification Method:
Affinity Chromatography
Regulatory Status:
RUO
Gene ID (Entrez):
54474
Content And Storage:
-20° C, Avoid Freeze/Thaw Cycles
Form:
Lyophilized
Applications:
Immunohistochemistry (Paraffin), Western Blot
Clone:
OTI4B4
Formulation:
PBS with 8% trehalose and no preservative; pH 7.3
Gene Accession No.:
P35900
Gene Symbols:
KRT20
Immunogen:
Full length human recombit protein of human KRT20 produced in E.coli.
Quantity:
100 μg
Primary or Secondary:
Primary
Target Species:
Human
Product Type:
Antibody
Isotype:
IgG1
Antigen: KDR
Classification: Monoclonal
Conjugate: Unconjugated
Gene: KDR
Gene Alias: CD309, FLK1, VEGFR, VEGFR2
Host Species: Mouse
Purification Method: Affinity Chromatography
Regulatory Status: RUO
Gene ID (Entrez): 3791
Content And Storage: -20° C, Avoid Freeze/Thaw Cycles
Form: Lyophilized
Applications: Western Blot
Clone: OTI2D7
Formulation: PBS with 8% trehalose and no preservative; pH 7.3
Gene Accession No.: P35968
Gene Symbols: KDR
Immunogen: Human recombit protein fragment corresponding to amino acids 786-1356 of human KDR produced in HEK293T cell.
Quantity: 100 μg
Primary or Secondary: Primary
Target Species: Human
Product Type: Antibody
Isotype: IgG2a
Antigen:
KDR
Classification:
Monoclonal
Conjugate:
Unconjugated
Gene:
KDR
Gene Alias:
CD309, FLK1, VEGFR, VEGFR2
Host Species:
Mouse
Purification Method:
Affinity Chromatography
Regulatory Status:
RUO
Gene ID (Entrez):
3791
Content And Storage:
-20° C, Avoid Freeze/Thaw Cycles
Form:
Lyophilized
Applications:
Western Blot
Clone:
OTI2D7
Formulation:
PBS with 8% trehalose and no preservative; pH 7.3
Gene Accession No.:
P35968
Gene Symbols:
KDR
Immunogen:
Human recombit protein fragment corresponding to amino acids 786-1356 of human KDR produced in HEK293T cell.
Quantity:
100 μg
Primary or Secondary:
Primary
Target Species:
Human
Product Type:
Antibody
Isotype:
IgG2a
Antigen: OTC
Classification: Monoclonal
Conjugate: Unconjugated
Gene: OTC
Gene Alias: OCTD
Host Species: Mouse
Purification Method: Affinity Chromatography
Regulatory Status: RUO
Gene ID (Entrez): 5009
Content And Storage: -20° C, Avoid Freeze/Thaw Cycles
Form: Lyophilized
Applications: Western Blot
Clone: OTI2G6
Formulation: PBS with 8% trehalose and no preservative; pH 7.3
Gene Accession No.: P00480
Gene Symbols: OTC
Immunogen: Human recombit protein fragment corresponding to amino acids 33-354 of human OTC produced in SF9 cell.
Quantity: 100 μg
Primary or Secondary: Primary
Target Species: Human
Product Type: Antibody
Isotype: IgG2a
Antigen:
OTC
Classification:
Monoclonal
Conjugate:
Unconjugated
Gene:
OTC
Gene Alias:
OCTD
Host Species:
Mouse
Purification Method:
Affinity Chromatography
Regulatory Status:
RUO
Gene ID (Entrez):
5009
Content And Storage:
-20° C, Avoid Freeze/Thaw Cycles
Form:
Lyophilized
Applications:
Western Blot
Clone:
OTI2G6
Formulation:
PBS with 8% trehalose and no preservative; pH 7.3
Gene Accession No.:
P00480
Gene Symbols:
OTC
Immunogen:
Human recombit protein fragment corresponding to amino acids 33-354 of human OTC produced in SF9 cell.
Quantity:
100 μg
Primary or Secondary:
Primary
Target Species:
Human
Product Type:
Antibody
Isotype:
IgG2a